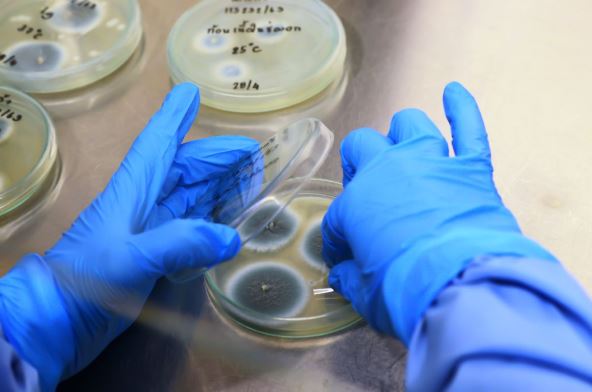
budj 2.jpg

Laura Šefer iz Pensilvanije provela je više od decenije u borbi sa nizom bolnih i iscrpljujućih simptoma, ne sluteći da je pravi uzrok sve vreme bio oko nje – i u njoj. Tek nakon niza pogrešnih dijagnoza, nepotrebnih operacija i godina fizičke i psihičke patnje, otkrila je da je njeno zdravlje uništavalo trovanje buđi.
Priča počinje 2012. godine, kada je Laura, tada u ranim dvadesetim, započela novu životnu etapu – uselila se u više od 100 godina staru farmu i stupila na novo radno mesto.
Iako je bila puna entuzijazma, radost je ubrzo zasenjena prvim simptomima: osećajem sličnim urinarnoj infekciji (bez prisustva infekcije), neobjašnjivim povišenim temperaturama, hroničnim umorom i mentalnom maglom.
Često je dobijala virusne infekcije, a opšti osećaj slabosti pripisivala je stresu, novom poslu i "realnosti života". Međutim, simptomi su se samo delimično povukli nakon što je napustila staru farmu, a zdravstveno stanje nastavilo da se pogoršava.
Tokom narednih godina Laura je više puta menjala mesto boravka, rodila decu, dojila, menjala poslove – ali joj je telo sve teže funkcionisalo. Nakon preseljenja na novu farmu 2018. godine, simptomi su eksplodirali. Lista tegoba obuhvatala je iscrpljujuće menstrualne cikluse, rektalna krvarenja, jake bolove u stomaku, dijareju, lupanje srca, izražene alergijske reakcije na hranu, otežano disanje, gubitak telesne mase i niz neuroloških problema.
Bila je na pregledima kod urologa, kardiologa, gastroenterologa, ginekologa, ali niko nije uspeo da poveže sve simptome u jednu celinu. Prošla je kroz dva kolonoskopijska pregleda, endoskopiju, magnetske rezonance, CT skenere, ultrazvuke, laboratorijske analize, hormonske panele, operaciju uklanjanja endometrioze, pa čak i histerektomiju i uklanjanje slepog creva.

"Duboko žalim zbog histerektomije", priznaje Laura danas. "Lekari su verovali da su moji simptomi posledica endometrioze i adenomiotičnih promena, ali rezultati operacije nisu potvrdili očekivanja. Osim što nije rešila problem, operacija je pogoršala hormonski disbalans."
Propisivani su joj antibiotici, beta-blokatori, hormonski preparati, dodaci ishrani i posebne dijete – ali olakšanje nikada nije došlo.
Tek u jesen 2024. godine, tokom jednog od najtežih pogoršanja, njen funkcionalni lekar postavio je pitanje koje niko pre njega nije postavio: Gde ste bili poslednjih dana? Kada je pomenula da je boravila u porodičnoj kući staroj 200 godina, lekar je predložio testiranje na prisustvo mikotoksina – otrovnih supstanci koje luče određene vrste buđi.
Rezultati su bili šokantni: svi glavni mikotoksini bili su ekstremno povišeni. Eksperimentisala je nekoliko meseci, izbegavajući sve potencijalne okidače osim boravka u kući i štali. Simptomi su se vraćali gotovo odmah po ulasku u te prostore.
Stručnjaci veruju da je izloženost počela još u prvoj staroj kući pre 12 godina, kada je udisanjem spora došlo do kolonizacije buđi u njenom telu, a život na farmi sa stajama, senom i životinjskom posteljinom dodatno je pogoršao problem.
Prema rečima dr Ehsana Alija, interniste i gerijatrijskog specijaliste iz Beverli Hilsa, trovanje buđi "godinama ostaje ispod radara" jer simptomi liče na brojne druge bolesti – od autoimunih poremećaja do anksioznosti.
"Ako lekar ne postavi ciljana pitanja o životnom okruženju, vlažnim prostorijama, mirisu na vlagu ili ranijem prisustvu buđi, šansa da se na vreme prepozna uzrok gotovo ne postoji", kaže dr Ali.
Od trenutka kada je saznala pravu dijagnozu, Laura je izbacila sve izvore buđi iz svog života: prestala je da ulazi u štalu, ugradila pročistače vazduha i odvlaživače, prešla na ishranu punu sveže i čiste hrane, a kuću održava tako da bude potpuno suva i provetrena.
Rezultati su zadivljujući – tri meseca nije imala ni jedno rektalno krvarenje, mentalna jasnoća se vratila, a energija joj se značajno poboljšala. "Prvi put posle toliko godina osećam da kontrolišem svoje zdravlje", kaže Laura.

Oporavak će, međutim, trajati, jer je telo godinama bilo izloženo toksinima. Uprkos tome, napredak koji je postigla naziva "neverovatnim" i veruje da će povratiti život koji joj je buđ oduzela.
Laura danas svoju priču deli na društvenim mrežama (@back.acre.iron na TikToku), a njeni video-snimci beleže stotine hiljada pregleda. Povezala se sa mnogima koji prolaze kroz slična iskustva, a njen cilj je da ljudima skrati put do prave dijagnoze. Pročitajte i koja sredstva pomažu da se skine buđ sa zidova.
BONUS VIDEO:



